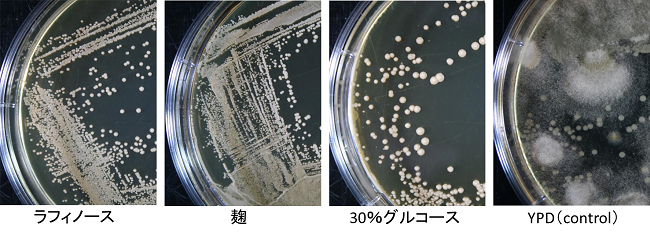
S. cerevisiae分離培地写真
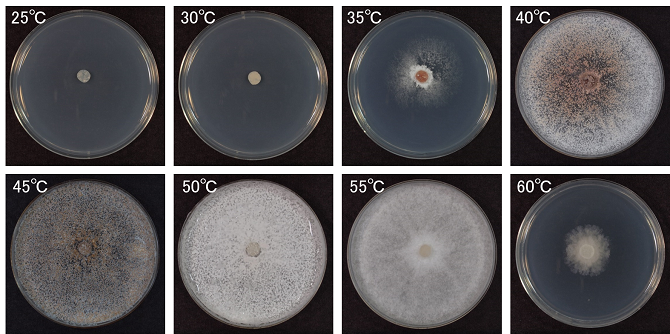
Thermoascus aurantiacus菌株の生育温度試験結果

NBRCニュース 第42号
◆◇◆ ━━━━━━━━━━━━━━━━━━━━━━━━━━━━━━━━ ◆◇◆
NBRCニュース No. 42(2016.12.1)
◆◇◆ ━━━━━━━━━━━━━━━━━━━━━━━━━━━━━━━━ ◆◇◆
NBRCニュース第42号をお届けします。今号は微生物の培養法、微生物あれこれの2つの
連載をお届けします。最後までお読みいただければ幸いです。
================================================================================
内容
================================================================================
1.新たにご利用可能となった微生物株
2.微生物の培養法(21)Saccharomyces cerevisiaeの選択分離法
3.微生物あれこれ(38)好熱性菌類
4.ヒトcDNAクローンのMTAフリー化のお知らせ
5.年末年始のNBRC微生物株・DNAリソースの発送休止について
================================================================================
1.新たにご利用可能となった微生物株
================================================================================
◆ NBRC株
糸状菌 79株、細菌 31株、アーキア 2株が新たにご利用可能となりました。
糸状菌には、カエルに病原性を示すBatrachochytrium dendrobatidis NBRC 112384~
NBRC 112387やVeronaea botryosa NBRC 109680~NBRC 109685と、その他に多数の子嚢菌
類ビョウタケ目の種が含まれます。
細菌では、Science誌で報告された石炭中のメトキシ芳香族化合物からメタンを生成す
るメタン生成古細菌Methermicoccus shengliensis NBRC 112467、同じくScience誌で報告
されたポリエチレンテレフタラート(PET)分解菌Ideonella sakaiensis NBRC 110686を
公開しました。
【詳細】 https://www.nite.go.jp/nbrc/cultures/nbrc/new_strain/new_dna.html
◆ RD株
樹木上の子実体(きのこ)などから分離された糸状菌・酵母339株を追加しました。そ
のうち75株はセルロース分解活性を示します。是非、リストをご覧ください。
【詳細】 https://www.nite.go.jp/nbrc/cultures/rd/new_rd.html
【RD株リスト】 https://www.nite.go.jp/nbrc/cultures/rd/available_rd_list.html
================================================================================
2.微生物の培養法(21)
Saccharomyces cerevisiaeの選択分離法 (山崎敦史)
================================================================================
ご存知のとおり、酵母はお酒やパンの製造等、何千年も遡る昔から人間の生活に利用さ
れている大変身近な微生物のひとつです。日頃NBRCに寄せられる菌株分譲の依頼や問合
せ、さらには論文や製品開発に関する記事にもS. cerevisiaeに関する内容が大変多いと
感じています。恐らく、お酒やパン等の製品開発のために花や果実等の自然環境中から
S. cerevisiaeの分離をお考えの方は少なくないのではないでしょうか。そこで本稿で
は、S. cerevisiaeの分離法について紹介したいと思います。
目的の微生物を分離するために考慮するポイントとして、分離源の種類、分離手法、分
離培地の選択が挙げられます。まず始めに、S. cerevisiaeが多く存在する基質を選ぶこ
とが重要なポイントになりますが、文献によるとS. cerevisiaeは植物、花、果実、樹
皮、樹液、昆虫、土壌、海水からも分離されていて特定のものに由来するわけではないよ
うです。そのため分離源の選び方からS. cerevisiaeの選択的な分離に繋げるのは難し
く、分離手法と分離培地の工夫が必要となります(1)。
酵母は一般に自然環境中の存在比率が細菌や糸状菌と比べると少ないので、増やすため
に集積培養法を利用します(2)。さらに、酵母は糸状菌に比べて乾燥ストレスへの耐性が
低く、貧栄養の環境の中で活性の低い飢餓状態で存在していると考えられるので、寒天培
地上における良好なコロニー形成が促進される液体培養を介します。
上記の集積培養法と、S. cerevisiaeの資化性や耐性などを考慮した条件に設定した選
択培地を組み合わせます。分離培地には、細菌に対する抗生物質としてクロラムフェニコ
ールと、糸状菌の増殖を抑えるプロピオン酸ナトリウムをそれぞれ加えます。既報の手法
を以下に概要説明します(一部の成分は既報の濃度と異なります)。
1. 炭素源の資化能を利用した方法
ラフィノースは、S. cerevisiaeが利用できる糖(炭素源)ですが、他の多くの酵母は
利用することができません。またエタノールの添加により、エタノール発酵能と耐性能を
有するS. cerevisiaeを優先して取得することができます(3)。
【培地組成】0.67% YNB (yeast nitrogen base) 、1% ラフィノース、0.01% クロラム
フェニコール、0.2% プロピオン酸ナトリウム、8% エタノール
【作製手順】エタノール以外の各成分を蒸留水に溶解。オートクレーブ滅菌(121℃・
20分)後、放熱・冷却してからエタノールを添加。
2. 清酒醸造法を参考にした方法
清酒醸造に使われるS. cerevisiaeと麹の相性の良さを利用する方法で、麹の成分であ
るプロテオリピドがS. cerevisiaeの増殖とエタノール発酵能を強化します。日本酒が、
ワイン・果実酒やビール等よりも高いエタノール濃度に高められるのはこのためだと報告
されています(4)。さらに、S. cerevisiaeの酸耐性を利用した「酒母(しゅぼ)」「も
と」造りを踏まえ、乳酸を加えることで、酸性条件を好まない他の微生物の増殖を抑制す
ることができます(5)。
【培地組成】麹汁(麹 200g、蒸留水 700ml)、0.2% 乳酸、0.01% クロラムフェニコー
ル、0.2% プロピオン酸ナトリウム
【作製手順】麹と蒸留水を混和し、55℃で1昼夜糖化。麹汁は、目の粗い布生地等と
ろ紙を組み合わせてろ過。クロラムフェニコール、プロピオン酸ナトリウ
ム、乳酸を加え、オートクレーブ滅菌(121℃・20分)。
3. 高濃度グルコースを利用した方法
Saccharomyces属は、学名が「砂糖の菌」を意味するように、グルコースを好む性質が
あり、S. cerevisiaeは60%グルコース入り寒天培地上で生育可能と報告されています。
この性質を利用し、他の多くの微生物が生育できない30%の液体培地で集積培養を行いま
す(6)。
【培地組成】1% 酵母エキス、2% ペプトン、30% グルコース、0.2% プロピオン酸ナト
リウム、0.01% クロラムフェニコール
【作製手順】各成分を蒸留水に溶解し、オートクレーブ滅菌(121℃・20分)。
集積培養の後、培養液を希釈してクロラムフェニコール及びプロピオン酸ナトリウムを
含むYPD寒天平板培地等に接種し、酵母コロニーを単離していきます。
ここで挙げた3種類の集積培地を用いて、土壌からS. cerevisiaeの分離を試みていま
す。その結果はまた次の機会にご紹介したいと思います。
図. 各種集積培地で25℃・2週間培養を行った後、抗生物質入り平板培地(YPD、0.01% クロラムフェニコール、
0.2% プロピオン酸ナトリウム) 上にストリークし、1週間培養した結果
紹介した3種類の培地で集積培養すると高確率でS. cerevisiaeコロニーが出現したが、YPD液体培地で集積
培養すると糸状菌やS. cerevisiae以外の酵母コロニーが多く出現した。
【文献】
(1) Vaughan-Martini, A. & Martini, A. (2011). In The yeasts: a taxonomic
study, 5th Edition, 2, 737-740.
(2) 横田 (1999). 新版 微生物学実験法 2, 26-28.
(3) Sampaio, J.P. & Goncalves, P. (2008). Appl. Environ. Microbiol., 74, 2144-
2152.
(4) 林田 (1990). 酵母のバイオサイエンス 9, 97-106.
(5) 吉浦, 田畑, 中川, 長谷川, 西岡 (2012). 茨城県工業技術センター研究報告 39.
(6) 鶴薗, 富永, 仲島, 横堀 (2005). 埼玉県産業技術総合センター研究報告 3.
================================================================================
3.微生物あれこれ(38)
好熱性菌類 (稲葉重樹)
================================================================================
原核生物には、生育のための最適温度が45℃以上である好熱菌(thermophiles)が多く
報告されています。一方で、真核生物には好熱性の種は非常に少ないのですが、菌類の特
に糸状菌(カビ)の中には比較的多くの好熱性種が知られています。今回は、その好熱性
菌類(thermophilic fungi)をご紹介します。
研究者によって好熱性菌類の定義はやや異なりますが、一般にCooney & Emerson
(1964) の定義が用いられます(1)。すなわち、最高生育温度が50℃以上で、最低生育温度
が20℃以上の種が好熱性とされています。最も高い生育温度を示す好熱性菌類は
Thermomyces lanuginosusやThermoascus aurantiacusなどで、62℃まで生育できます。一
方、約50℃の高温で生育可能で、20℃未満でもよく生育する種は高温耐性菌類
(thermotolerant fungi)として区別されます。Aspergillus fumigatusは代表的な高温
耐性菌です。なお、ここでいう高温耐性菌類は、加熱加工食品の汚染で問題となる耐熱性
菌類(heat resistant fungi)とは定義が異なります。
菌類には現在までに約10万種が知られていますが、そのほとんどは生育温度範囲が10~
40℃で25~35℃程度の最適生育温度をもつ中温性菌(mesophiles)です。好熱性の種は、
de Oliveira et al. (2015) のリストアップによれば、わずか19属44種にすぎません(2)。
そのほとんどは子嚢菌類で、特にユウロチウム目Eurotialesとフンタマカビ目
Sordarialesの属・種が多く、その他に接合菌類ケカビ目MucoralesのRhizomucorや
Thermomucorなどの属の種が含まれます。好熱性菌類の分類は、多数の同物異名(シノニ
ム)が記載されたことなどに起因して長らく混乱していましたが、最近の系統分類学的研
究成果にもとづき分類体系の再編・整理が進められています。しかしその結果、応用研究
などに用いられてきた種の多くは転属などによって菌名が変更されており、文献を参照す
る際には注意が必要となっています。
好熱性菌類はさまざまな環境に広く分布しています。堆肥や積みあげた藁や木材チップ
など、発酵熱が生じる環境から多く分離されるほか、森林や畑の土壌、湖沼や水田の底泥
からも分離することができます。また、鳥の巣材や石炭ボタ山などからも報告されていま
す。多くの種は特別な栄養要求性を示さないため、ポテトデキストロース寒天培地などの
一般的な培地を用いて容易に分離・培養することができます。培養株を用いた生理学的研
究や細胞学的研究が多く行われていますが、好熱性菌類の熱耐性の機構は必ずしも十分に
解明されてはいないようです。
最近になって、好熱性菌は応用利用の面からも重要視されています(3)。特に、産業上
重要な熱安定性に優れ高い反応至適温度をもつアミラーゼ、セルラーゼ、キシラナーゼ、
リパーゼ、プロテアーゼ、フィターゼなどの酵素の探索源として、好熱性菌類が注目され
ています。さらに、これらの酵素を、植物バイオマスを糖化してバイオエタノール生産に
利用する研究や、土壌改良に利用する研究が行われています。2011年以降、好熱性菌類の
代表種のゲノム解析が進行していることから、今後ますます好熱性菌類の機能研究や応用
研究が発展するものと期待されます。
NBRCでは好熱性菌類の菌株を多数分譲しております。ぜひ、好熱性菌類の基礎研究や応
用研究にご利用ください。
図. Thermoascus aurantiacus菌株の生育温度試験結果(PDA平板、含菌寒天片一点接種、培養3日目) 40~55℃で生育良好、40℃と45℃の平板では赤褐色粒状の子嚢殻が形成され始めている。 【文献】 (1) Cooney, D.G. & Emerson, R. (1964). Thermophilic fungi, W.H. Freeman & Co. (2) de Oliveira, T.B. et al. (2015). Extremophiles, 19, 31-37. (3) Singh, B. et al. (2016). Crit. Rev. Microbiol., 42, 985-1006. ================================================================================ 4.ヒトcDNAクローンのMTAフリー化のお知らせ ================================================================================ NBRCから分譲している約5万2千のヒトcDNAクローンのうち、これまでその一部(153ク ローン)は、ご依頼時に分譲依頼書及び同意書の提出に加えてMTA(Material Transfer Agreement)の締結が必要でしたが、平成28年10月より、全てのクローンについてMTAなし (MTAフリー)でご利用いただけるようになりました。下記リンク先にMTAフリーとなった 153個のクローンリストを掲載しております。これまでMTAのために依頼を躊躇されていた 方もいらっしゃったと思います。是非一度ご確認ください。 注:制限付き寄託のクローンにつきましては、引き続きご依頼時に誓約書が必要となりま す。ご注意ください。 【MTAフリーとなったクローンリスト】 https://www.nite.go.jp/nbrc/cultures/information/20161125.html ================================================================================ 5.年末年始のNBRC株・DNAリソースの発送休止について ================================================================================ NBRCでは下記の年末年始期間中、送付後の微生物の品質を確保するため、NBRC株・DNA リソースの発送を一時休止させていただきます。 発送休止期間:平成28年12月26日(月)~ 平成29年1月4日(水) 発送予定: 12月21日(水)午前まで受付分 → 12月22日(木)発送 12月21日(水)午後~12月28日(水)まで受付分 → 1月5日(木)発送 12月29日(木)以降の受付 → 1月12日(木)以降発送 なお、年内の営業日は12月28日(水)まで、年始は1月4日(水)からとなります。 【詳細】 https://www.nite.go.jp/nbrc/cultures/index.html ================================================================================ 編集後記 ================================================================================ 日本滞在経験のある外国人に出会うと、日本で不思議に思ったことは何か、という質問 をするのですが、秋冬の木々に関して、タイ人は落葉して木が裸になることを不思議と言 い、モンゴル人は冬になっても葉が落ちない木を見て不思議と言いました。同じ景色を見 ても、視点の置き方によって見え方は変わるということを実感しました。12月を迎え、本 格的な冬に向けてぐっと気温が下がってきました。場所によってはまだ紅葉が楽しめる様 子。日本ならではの風物詩を楽しみたいと思います。(MM) ◆◇◆ ━━━━━━━━━━━━━━━━━━━━━━━━━━━━━━━━ ◆◇◆ ・画像付きのバックナンバーを以下のサイトに掲載しております。受信アドレス変更、 受信停止も以下のサイトからお手続きいただけます。 https://www.nite.go.jp/nbrc/cultures/others/nbrcnews/nbrcnews.html ・NBRCニュースは配信登録いただいたメールアドレスにお送りしております。 万が一間違えて配信されておりましたら、お手数ですが、下記のアドレスにご連絡く ださい。 ・ご質問、転載のご要望など、NBRCニュースについてのお問い合わせは、下記のアドレ スにご連絡ください。 ・掲載内容は予告なく変更することがございます。掲載内容を許可なく複製・転載され ることを禁止します。 ・偶数月の1日(休日の場合はその前後)に配信します。第43号は2017年2月1日に配 信予定です。 編集・発行 独立行政法人製品評価技術基盤機構(NITE)バイオテクノロジーセンター NBRCニュース編集局(nbrcnews@nite.go.jp) ◆◇◆ ━━━━━━━━━━━━━━━━━━━━━━━━━━━━━━━━ ◆◇◆
FLASHファイルをご覧いただくためには、Adobe Flash Player(無償)が必要です。Adobe Flash Playerはダウンロードページ![]() よりダウンロードできます。
よりダウンロードできます。
お問い合わせ
-
独立行政法人製品評価技術基盤機構 バイオテクノロジーセンター
生物資源利用促進課
(お問い合わせはできる限りお問い合わせフォームにてお願いします) -
TEL:0438-20-5763
住所:〒292-0818 千葉県木更津市かずさ鎌足2-5-8 地図
お問い合わせフォームへ








